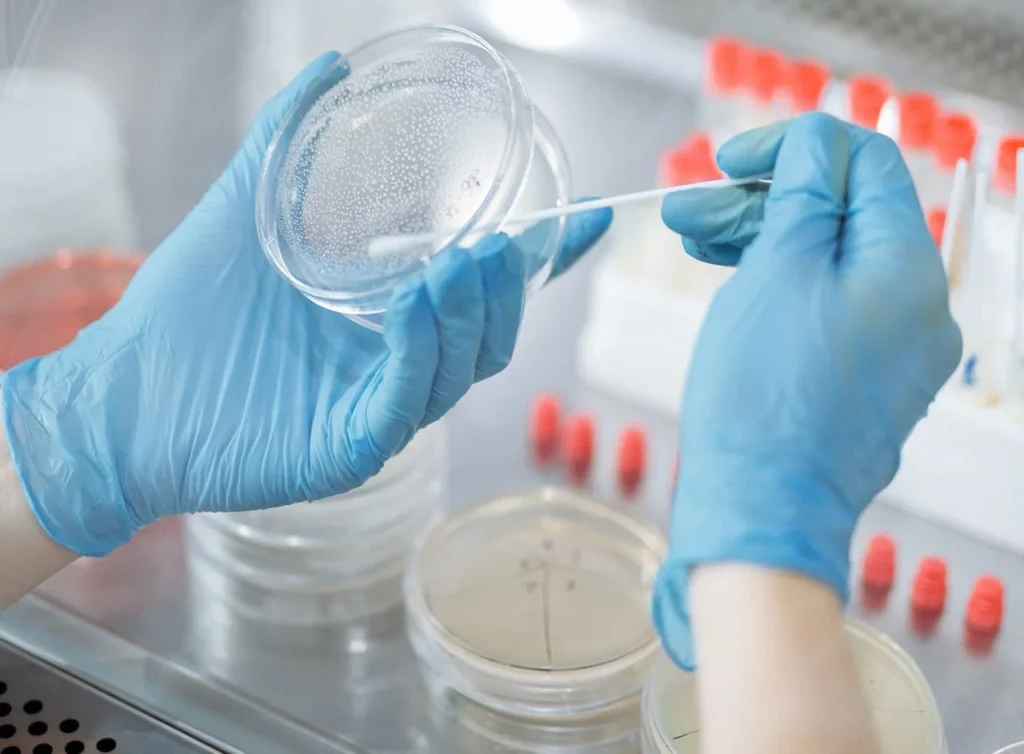
legionella+testing+and+analysis

Our Story
A Message from Chris Burke
When Chris Burke launched SWP International in 2000, it was not just a business venture—it was a heartfelt project for a customer that blossomed into something far greater than he could have ever imagined. His vision was always about more than just offering a product; it was about creating a meaningful impact, rooted in the genuine desire to help everyone and make a positive difference in their lives.
In 2024, due to popular demand, Safe Water Products BV decided to provide products for the US market, driven by the passion to educate and support community members affected by chronic lung diseases such as NTM, Bronchiectasis, Legionnaires’ Disease and many more. We emphasize the importance of incorporating water filtration products into daily life as a part of a holistic solution to health and well-being.
Our Mission
Our mission is to ensure that everyone can afford access to high-quality water filtration products.
At the core of everything we do is a desire to inspire brighter days for all. This is why we are dedicated to not only producing the best and most affordable water filtration products, but also giving back to organizations that create meaningful impacts in communities, including NTM.
The Water Filter Products Promise
We deeply care about what you breathe in. This is why we meticulously examine thousands of products, testing each one to guarantee that our products are certified by the finest laboratories, safe, and provide exceptional value and results. We want to give you the peace of mind to focus on what truly matters in your life.
Our Philosophy
Our philosophy is rooted in the belief that everyone deserves access to top-quality, affordable water filtration products. We strive to alleviate worries about water quality and high costs by providing effective, structural solutions. Our aim is to help you embrace life fully, with one less thing to worry about.